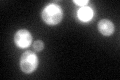
YIR012W
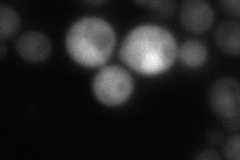
YIR012W
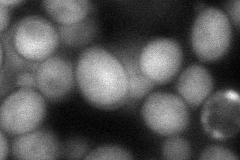
YIR012W
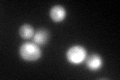
YIR012W

View description
Essential protein involved in a late step of 60S ribosomal subunit assembly or modification; contains multiple WD repeats; interacts with Qsr1p in a two-hybrid assay
Localization:
Intensity:
Fold change:
Significance:
-
C’ GFP library in SD
nucleus:cytosol102.8 -
N' NOP1pr-GFP in SD

cytosol155.412 -
N' TEF2pr-mCherry in SD

nucleus227.167 -
N' NATIVEpr-GFP in SD
nucleus62.5323 -
N' TEF2pr-VC and Cyto-VN in SD
cytosol65.4033 -
C’ GFP library in SD+DTT
nucleus.cytosol83.90.81No -
C’ GFP library in SD+H2O2

nucleus.cytosol120.41.17No -
C’ GFP library in Starvation Media

nucleus,cytosol60.380.58Yes -
C’ GFP library on the background of Pup2-DaMP

nucleus:cytosol -
C’ GFP library on the background of CCT mutant

nucleus:cytosol104.6571.01797No
